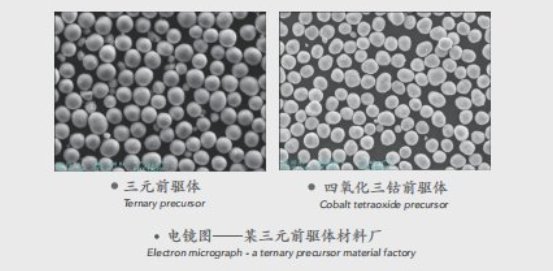
image.png

湖南经源科技有限公司
金牌会员
已认证

湖南经源科技有限公司
金牌会员
已认证






点击留言,第一时间获取专属报价
经源科技分子生物学仪器
经源科技MHR多效反应机1
分子生物学仪器
产品介绍
MHR多效反应机是一款针对锂电池正极前驱体,开发的新型强化反应设备,由多效混合器和强化反应釜组成,可实现多种液体快速、强效的混合反应。
设备组成
MHR多效反应机主要由原料输送泵、多效混合器、循环泵、强化反应釜等组成。其应用场景丰富,既可用于新建项目,也可通过适当改造用于现有项目的提质升级。

知识产权
MHR多效反应机已申请并获得多项**,其中,***2项,实用新型**9项。
工作原理
MHR多效反应机利用溶液泵将相应的液体泵送至自主研发的多效混合器中,在混合器中实现推流式混合反应后,进入强化反应釜,并在强化反应釜中完成流体对撞、剪切和扩散混合,快速增大溶质离子与晶体的接触面积,促进晶体的生长发育,得到粒度及形貌均一、发育良好的晶体颗粒。

产品特点
产品形貌均匀一致
1、**产品一多效反应装置,使多相流体在多效反应装置中实现推流式混合反应,混合强度高,粒度分布窄。
2、流体搅拌,区别于传统反应釜的机械搅拌,强化反应釜采用流体搅拌,可实现对撞、涡流和扩散等混合,溶液分布均匀,颗粒发育良好。

无金属杂质污染
1、强化反应釜及管道全部采用高性能塑料材质,避免金属杂质污染;
2、采用流体均相搅拌技术,无搅拌轴及叶片,避免由于搅拌磨损而产生磁性物质污染。
智能化程度高,可精确控制溶液流量及混合强度,获取工艺需求的产品形貌;
高品质、低维护,运行稳定可靠。
产品规格表

应用场景
MHR多效反应机可用于新建或现有项目。在新建项目中,可为客户提供整套反应机系统或单独的多效反应机模块,在现有项目中,可为客户提供多效混合器,提升产品品质及反应速率。

MHR多效反应机的工作原理介绍?
MHR多效反应机的使用方法?
MHR多效反应机多少钱一台?
MHR多效反应机的说明书有吗?
MHR多效反应机的报价含票含运费吗?
MHR多效反应机有现货吗?
MHR多效反应机是国产还是进口的?
有MHR多效反应机的详细技术参数吗?
MHR多效反应机可以应用在哪些领域?
波莫纳有办事机构吗?
波莫纳销售电话是多少?相关产品
更多
相关方案
更多
企业名称
湖南经源科技有限公司企业类型
有限责任公司(自然人投资或控股)信用代码
91430100MAC1LWYN6Q法人代表
范永超注册地址
长沙高新开发区麓云路100号兴工科技园1栋505-1成立日期
2022-10-13注册资本
800万元有效期限
2022-10-13 至 无固定期限经营范围
一般项目:应用软件开发;机械设备研发;通用设备制造(不含特种设备制造);除尘技术装备制造;物料搬运装备制造;包装专用设备制造;机械电气设备制造;工业机器人制造;矿山机械制造;专用设备制造(不含许可类专业设备制造);工业自动控制系统装置制造;泵及真空设备制造;液气密元件及系统制造;液压动力机械及元件制造;物料搬运装备销售;智能基础制造装备销售;特种设备销售;智能机器人的研发;智能机器人销售;普通机械设备安装服务;技术服务、技术开发、技术咨询、技术交流、技术转让、技术推广;货物进出口;技术进出口;计算机软硬件及辅助设备批发;计算机软硬件及辅助设备零售;计算机软硬件及外围设备制造;软件开发;海洋工程装备研发。(除依法须经批准的项目外,自主开展法律法规未禁止、未限制的经营活动)许可项目:建设工程施工。(依法须经批准的项目,经相关部门批准后方可开展经营活动,具体经营项目以批准文件或许可证件为准)
400-810-0069转1615
MHR多效反应机由湖南经源科技有限公司提供,产地为湖南,属于国产分子生物学仪器,符合多项国家和国际标准,广泛应用于石油/化工、建材/涂料/油漆、综合其他等领域,MHR多效反应机凭借其创新性与实用性,在分子生物学仪器用户中获得广泛关注。
据中国粉体网显示:该产品已通过粉体网认证,在产品性能、服务能力等维度表现优异,用户平均评分达9.5(满分 10 分),入选分子生物学仪器近30天热度榜。
根据经源科技官方产品资料显示:MHR多效反应机的型号是MHR多效反应机1,品牌为湖南经源。
请拨打厂商400电话进行咨询
使用微信扫码拨号
